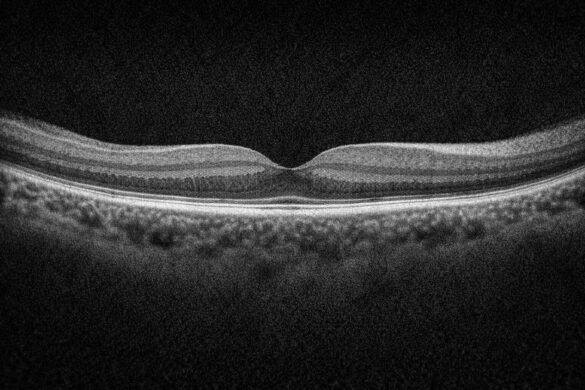

OCT(光干渉断層計)は眼科診療に欠かせない検査機器ですが、どのモデルを導入すべきか迷う方も多いのではないでしょうか。
今回は、日本国内で導入例が多い ニデック社のRS-330 と、グローバルスタンダード機 ZEISS社のCIRRUS を徹底比較して、それぞれの特徴や性能差についてまとめます。
価格と立ち位置の違い
- RS-330:価格は比較的手頃。導入しやすい。
- CIRRUS:価格は高めだが、世界中で使用されるスタンダード機。
共通して表示可能なOCT指標
黄斑部(GCC)
- GCC厚マップ(Thickness Map):両機種対応
- Deviation Map(正常眼との比較):両機種対応
- セクター表示:RS-330は8または2分割、CIRRUSは6分割
→[CIRRUS OCTのGanglion Cell解析を徹底解説|GCL+IPLの意味とレポートの見方]
視神経乳頭(ONH)・RNFL

- RNFL厚マップ・Deviation Map:両機種対応
- C/D比、Disc面積、カップ体積など:両機種対応
- Rim評価はCIRRUSの方が充実
OCT-A(アンギオグラフィ)

両機種とも以下の血流構造の表示に対応しています:
- VRI(硝子体)
- Superficial(網膜表層)
- Avascular(網膜深層)
- ORCC(網膜外層〜脈絡毛細血管)
- Choroid(脈絡膜)
層の切り分けの明確さではCIRRUSに軍配です。
主要な違いまとめ
| 比較項目 | ZEISS CIRRUS | ニデック RS-330 |
|---|---|---|
| データベース | 人種別・Disc径考慮 | 一元的 |
| 画像鮮明度 | ◎ 非常に高精細 | ○ 標準(デノイジングで対応) |
| 近視眼対応 | なし | ◎ 長眼軸用DBあり(オプション) |
| OCT-Aの層分類 | ◎ 明瞭・論文にも準拠 | ○ 表示可だが分類やや単純 |
| コスト | △ 高価格帯 | ◎ コストパフォーマンス良好 |
近視の強い眼では、OCTの結果がうまく反映されないことがあり、それに対応するのが長眼軸長正常眼データベースです。→[ニデックOCT×長眼軸データベース活用法|眼軸長が測れない施設でも使える推定ツール]
RS-1(Gravas)の独自機能
- スキャン幅補正:眼軸長に応じて自動補正
- DLセグメンテーション:AIによる層の切り分け精度向上
まとめ:どちらを選ぶべきか?
精密検査・論文対応・国際基準を重視するならZEISS CIRRUS。
一方、日常診療で十分な性能を求め、コストも考慮したいならニデック RS-330は非常に優れた選択肢です。
0.5ミリ先 